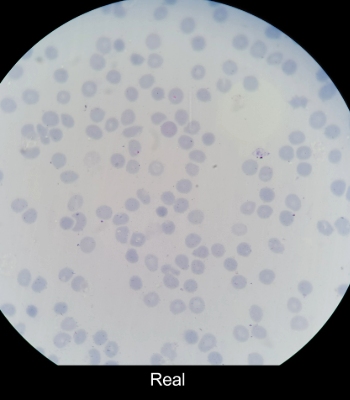
4

KI-Systeme zur Bildanalyse sind nur so gut wie die Daten, mit denen sie trainiert wurden. Das Göppinger Start-up MIRA Vision hat ein neuartiges Verfahren zur Erstellung synthetischer fotorealistischer Bilder entwickelt, durch das sich wesentlich effizienter als bisher umfangreiche und hochwertige Trainingsdatensätze erstellen lassen. Eine intuitive Plattform ermöglicht Forschenden zudem die unkomplizierte Auswertung von Mikroskopiebildern.
Viele medizinische Diagnosen basieren auf bildgebenden Verfahren wie MRT- oder CT-Scans, Röntgenaufnahmen oder Mikroskopiebildern. Diese enthalten eine Fülle an Informationen, deren Auswertung oft komplex und zeitintensiv ist. Zur Unterstützung von Ärztinnen und Ärzten kommen deshalb zunehmend Computerprogramme zum Einsatz, die Künstliche Intelligenz (KI) nutzen. Damit solche KI-Systeme zuverlässig arbeiten, müssen sie zuvor allerdings mit einer großen Anzahl an Musterlösungen trainiert werden. Diese entstehen aus geeigneten Beispielbildern, indem Expertinnen oder Experten in einem aufwendigen manuellen Prozess, dem sogenannten Annotieren, relevante Strukturen markieren. „Das Sammeln und Annotieren der erforderlichen Bilder ist extrem aufwendig und teuer“, erläutert Leonid Mill, CTO des Start-ups MIRA Vision. „Aus diesem Grund nutzen wir synthetische fotorealistische Bilder, die wir mit einem neuartigen Verfahren generieren können.“
Analyse von Mikroskopiebildern stellt hohe Anforderungen an Trainingsdaten
Insbesondere auf dem Gebiet der Histologie, also der mikroskopischen Untersuchung von Gewebeproben, besitzen KI-basierte Anwendungen großes Potenzial. Die Algorithmen segmentieren die Mikroskopieaufnahmen, das heißt, jeder Bildpunkt wird einem Objekt zugeordnet. Dies ermöglicht die Erkennung von feinsten Strukturen und komplexen Mustern, wodurch sich pathologische Veränderungen präzise, objektiv und schnell identifizieren lassen.
Foto: Leonid Mill (links) und Lukas Mürdter (rechts) von MIRA Vision nutzen synthetische fotorealistische Bilder, um KI-Systeme zur Analyse von Mikroskopiebildern zu trainieren. © NWZ
Der klassische Weg zu einem geeigneten KI-System ist jedoch beschwerlich. Vor allem die Analyse detailreicher Mikroskopiebilder erfordert eine große Menge an qualitativ hochwertigen Trainingsdaten. Beim manuellen Annotieren ausgewählter Originalaufnahmen versehen Pathologinnen und Pathologen jede einzelne Struktur mit Informationen, beispielsweise zu Gewebeart, Gut- bzw. Bösartigkeit oder zum Färbegrad – ein Prozess, der pro Bild mehrere Tage dauern kann. Zum Erstellen eines verlässlichen Algorithmus, etwa zur Tumorerkennung, werden Millionen solcher Bilder oder -ausschnitte benötigt, die idealerweise viele Varianten von gesundem sowie krankem Gewebe repräsentieren. „Erschwerend kommt hinzu, dass zwischen Mikroskopen verschiedener Hersteller große Farb- und Kontrastunterschiede auftreten können“, ergänzt Lukas Mürdter, CEO des Göppinger Unternehmens. „Die KI muss daher mit Daten jedes einzelnen Mikroskops trainiert werden.“
Umfangreiche Datensätze aus synthetischen Bildern
Mit all diesen Herausforderungen hatte Mill auch während seiner Zeit bei Prof. Dr. Andreas Maier am Lehrstuhl für Mustererkennung der Friedrich-Alexander-Universität Erlangen-Nürnberg (FAU) zu kämpfen. Dort arbeitete er an verschiedenen Forschungsprojekten zu KI-unterstützter Bildanalyse im medizinischen Bereich. Der Mechatroniker schildert: „Um schneller und mit deutlich weniger Aufwand an das benötigte Datenmaterial zu gelangen, habe ich eine alternative Technologie entwickelt. Mit dieser können wir jetzt fotorealistische Bilder erzeugen. Also synthetische Bilder, die nicht von realen Mikroskopieaufnahmen zu unterscheiden sind.“

Bild: Das mit dem innovativen Verfahren von MIRA Vision generierte synthetische Bild eines angefärbten Lungengewebes (links) lässt sich nicht von einer echten Mikroskopieaufnahme (rechts) unterscheiden. © MIRA Vision Microscopy GmbH
Zunächst werden mit Hilfe spezialisierter Software einzelne Gewebebestandteile wie Zellen, Fasern, Bindegewebe und auch Artefakte und Farbvarianten manuell simuliert, also ohne den Einsatz generativer KI. Als Vorlage dienen Originalaufnahmen und Abbildungen aus Lehrbüchern, wissenschaftlichen Publikationen sowie dem Internet. Aus diesen Grundbausteinen entstehen dann Bilder von gefärbten Gewebeausschnitten mit unterschiedlichen Texturen. In einem iterativen Prozess zusammen mit erfahrenen Pathologinnen und Pathologen werden diese anschließend so lange verfeinert, dass selbst Fachleute keinen Unterschied mehr zu realen Aufnahmen erkennen können.
Basierend auf den Simulationen lassen sich in kürzester Zeit unzählige Datensätze erstellen, mit denen KI-Modelle effizient trainiert werden können. „Der große Vorteil unserer Technologie besteht darin, dass jeder Bildpunkt durch eine mathematische Funktion definiert ist“, hebt Mill hervor. „So können wir alle denkbaren Variationen generieren – die ideale Grundlage für ein verlässliches KI-System.“ Durch den Verzicht auf reale Patientendaten entfalle zudem die komplexe Problematik des Datenschutzes, so Mürdter.
Die Leistungsfähigkeit des neuartigen Ansatzes belegen Mill und seine Kolleginnen und Kollegen von der FAU Erlangen-Nürnberg in einer Publikation, die im März 2025 erschienen ist.1) Am Beispiel von gefärbten Muskelpräparaten zeigen die Forschenden, dass ein mit synthetischen Bildern trainiertes KI-System dem auf Grundlage von realen Daten sogar überlegen sein kann. Die Segmentierung, also die präzise Objektzuordnung der einzelnen Bildpunkte, ist qualitativ hochwertiger und erreicht das Niveau medizinischen Fachpersonals.
Benutzerfreundliche MIRA AI Plattform
Bereits Ende 2020 lieferte das innovative Verfahren erste vielversprechende Ergebnisse. Als Mill seinem Schwager Mürdter davon berichtete, erkannte der gelernte Wirtschaftsfachwirt und damalige Geschäftsführer eines IT-Dienstleisters das unternehmerische Potenzial der Technologie, und die beiden gründeten im Mai 2021 die MIRA Vision Microscopy GmbH. Mit finanzieller Unterstützung durch private Investoren und staatliche Fördermittel, beispielsweise im Rahmen des europäischen Projekts BioMan4R2 sowie einem Innovationsgutschein HighTech BW, entstand in den folgenden Jahren die webbasierte MIRA AI Plattform. Sie macht die automatisierte Bildauswertung vielen Nutzenden zugänglich, aktuell auf dem Gebiet der Muskelhistologie. Forschende können eigene Bilder hochladen und diese ohne spezielles Vorwissen quantifizieren lassen. Mill erklärt: „Das System erfasst präzise, wie viele Zellen und Zellkerne vorhanden sind, und wie hoch der Anteil von Bindegewebe ist. All diese Metriken liefern wichtige Hinweise auf das Geschehen im Gewebe.“ Die Informationen lassen sich nutzen, um die Auswirkungen von Medikamenten, Krankheiten oder anderen Faktoren auf das Gewebe zu bestimmen. Diverse universitäre Forschungsgruppen in Deutschland, Österreich und Kanada haben die Plattform bereits erfolgreich angewandt.
Auch Forschungseinrichtungen wie das Deutsche Zentrum für Luft- und Raumfahrt (DLR) profitieren von der Technologie. So analysierte MIRA Vision sämtliche Muskelgewebeschnitte für die von NASA, ESA und dem DLR durchgeführte Bettruhestudie AGBRESA, die die Auswirkungen von künstlicher Schwerkraft auf die Gesundheit von Astronautinnen und Astronauten untersuchte.2)
Breites Anwendungsspektrum
Die patentierte Methode zum Training von KI-Systemen ist weltweit einzigartig. 2023 gewann das inzwischen auf zehn festangestellte Mitarbeiter angewachsene Unternehmen den Innovations- und Unternehmerpreis Göppingen, und 2024 wurde es als KI-Champion Baden Württemberg ausgezeichnet. MIRA Vision ist Teil des renommierten KI-Forschungskonsortiums Cyber Valley sowie Portfolio-Unternehmen der Bundesagentur für Sprunginnovationen (SPRIND).
Aktuell arbeitet das Start-up an Projekten im Bereich der Lungen-, Brust- und Gebärmutterhalshistologie. Für Pathologinnen und Pathologen bietet die detaillierte Beschreibung der einzelnen Zellen einen echten Mehrwert und könnte ihnen bei der Identifizierung von Krankheitsmarkern helfen. Langfristig sollen die KI-Systeme in der klinischen Diagnostik eingesetzt werden. Denn neben der Quantifizierung ist auch die Klassifizierung der Zellen anhand einer veränderten Morphologie möglich, ein wichtiger Schritt zur Erkennung von Krankheiten. Das Verhältnis zwischen gesunden und kranken Zellen könnte zudem als Marker für den Verlauf einer Erkrankung dienen.
Nicht nur Gewebeschnitte, sondern auch Blutausstriche lassen sich mit der Göppinger Technologie untersuchen, etwa zur Detektion von Malaria-infizierten Zellen. „Weltweit gibt es nur wenige Fachleute für die Malariaerkennung. Wir möchten dazu beitragen, dass jede Person Zugang zu einer kostengünstigen Diagnostik erhält“, sagt Mürdter. „Das Sammeln von Realdaten aus aller Welt zum Trainieren einer KI würde Jahre dauern.“ Dank seiner innovativen Technologie und des großen Expertennetzwerks kann MIRA Vision aber innerhalb weniger Wochen für jedes Anwendungsgebiet ein leistungsfähiges KI-System zu entwickeln.
Bild: Das Göppinger Unternehmen kann auch Blutausstriche simulieren, beispielsweise für die Malaria-Diagnostik. Im synthetischen Bild (oben) sind neben roten Blutzellen und Blutplättchen auch weiße Blutzellen (größer und mit dunklem Kern) zu sehen. © MIRA Vision Microscopy GmbH
Quellen:
1) Mill, L. (2025). Deep learning-based image analysis in muscle histopathology using photo-realistic synthetic data. Communications medicine, 5(1), 64. https://doi.org/10.1038/s43856-025-00777-y
2) The European Space Agency (2019): Bettruhestudie AGBRESA. https://www.esa.int/Space_in_Member_St ... esundheit_von_Astronauten
Quelle: Dr. Ruth Menßen-Franz, © BIOPRO Baden-Württemberg GmbH
Symbolbild: Adisak / AdobeStock










